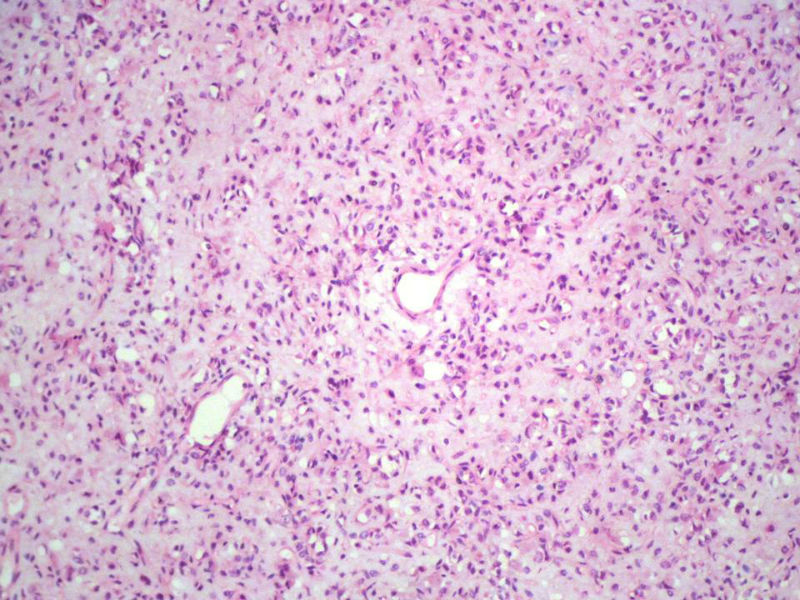
右股骨上段皮下肿物,新加免疫组化图10 右股骨上段皮下肿物,新加免疫组化图10
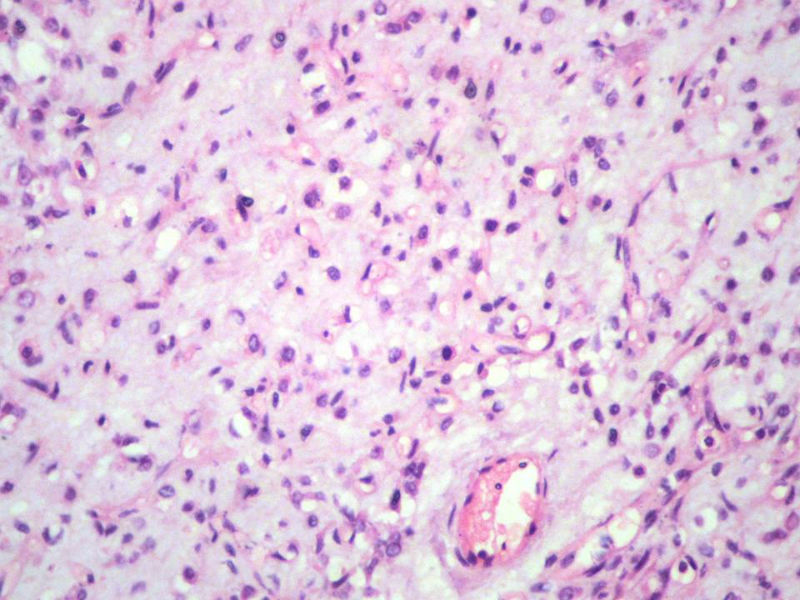
右股骨上段皮下肿物,新加免疫组化图12 右股骨上段皮下肿物,新加免疫组化图12

男,27岁,右股骨上段皮下肿物1年余,无明显疼痛,检查肿物明显隆起于皮下,边界清楚,手术完整切除肿物。肉眼,肿物6X6X5厘米,外观多结节状,似有包膜,切面灰白色,质韧。
特别提示:镜下核分裂3-4/HP.

名称:图1
描述:幻灯片2

名称:图2
描述:幻灯片3

名称:图3
描述:幻灯片4

名称:图4
描述:幻灯片5

名称:图5
描述:幻灯片6

名称:图6
描述:幻灯片7

名称:图7
描述:幻灯片8

名称:图8
描述:幻灯片9

名称:图9
描述:幻灯片10
名称:图10
描述:幻灯片11

名称:图11
描述:幻灯片12
名称:图12
描述:幻灯片13

名称:图13
描述:幻灯片14

名称:图14
描述:幻灯片15

名称:图15
描述:幻灯片16

名称:图16
描述:幻灯片17